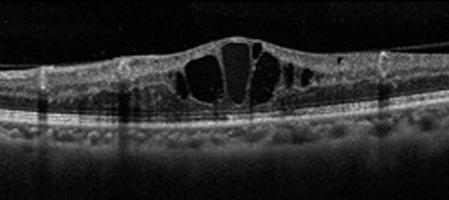
黄斑浮腫

網膜静脈閉塞症とは?
網膜静脈閉塞症は、静脈の血管が詰まる病気です。
詰まる部位によって、「網膜中心静脈閉塞症」「網膜静脈分枝閉塞症」に分けられます。


網膜の血管が詰まると、静脈から網膜に血液成分が漏れだし、出血が生じ、網膜の中心である黄斑に水があふれて腫れます。
これを黄斑浮腫と言い、網膜静脈閉塞症の視力低下の原因です。
原因
高血圧になると動脈が硬くなり、接している静脈を圧迫して血栓ができやすくなります。高血圧の他には、糖尿病・高コレステロール血症の人が発症しやすいです。網膜静脈閉塞になったら、全身検査をする必要があります。
網膜中心静脈閉塞症
中心静脈という網膜静脈の根元で詰まります。あふれ出た血液が網膜全体に広がります。急激な視力低下が起こり、黄斑部の浮腫が起こるとゆがみが見られ、視力も下がります。

合併症
硝子体出血

閉塞により血液の流れが途絶えた部分に毛細血管の代わりとして「新生血管」と呼ばれる本来は存在しない異常な血管が生まれます。新生血管はもろく破れやすいので、いろいろな合併症を起こします。
年齢の変化で硝子体が網膜から離れるとき、この新生血管が引っ張られて、硝子体出血を引き起こします。硝子体出血を生じると、墨を垂らしたようなものが見えたのちに、全体が見えなくなります。
網膜裂孔
血が流れなくなった網膜は薄くなります。年齢的な変化で硝子体が網膜から離れる時、この薄くなった網膜が引っ張られて、孔ができ、網膜裂孔や剥離になります。
血管新生緑内障

一番困る合併症は血管新生緑内障になることです。血液が流れない領域(無血管領域)が拡がると悪い新生血管が出来て隅角をふさぎ、とても高い眼圧になります。視野や視力を失うだけでなく、眼圧が上がったために、眼の痛みや頭痛が耐え難いものになります。無血管野が拡がったら、早いうちに広い範囲の光凝固術が必要になります。
治療
01.黄斑部の浮腫に対しては抗VEGF薬硝子体注射
効果的ですが、効果が3か月くらいしか続かず何度も注射する場合があります。
02.網膜中心静脈閉塞症に対しては網膜光凝固術
無血管野から新生血管が出来るのを抑えるために網膜全体に光凝固をします。
レーザーの詳細は網膜レーザー治療のページをご覧ください。
03.ステロイドテノン嚢下注射
結膜の下のテノン嚢にステロイドを注射し、むくみを取ります。
硝子体手術を行ったり複数の治療を組み合わせて行うこともあります。
糖尿病・高血圧のある方は、再発やもう片方の目にも起こすことがありますので基礎疾患を治すことが大切です。
網膜静脈閉塞よくある質問
網膜静脈閉塞と言われました。何か注意することがありますから?
動脈硬化が強くなる病気、高血圧・糖尿病・高脂血症など病気がある場合が多いです。全身的な検査を受けてください。
治療を受ければ、元通りに見えるようになりますか?
網膜静脈閉塞を発症して黄斑浮腫が起こると、眼が見にくくなります。その後の治療による回復は、閉塞した場所や期間によってさまざまです。
発症してすぐに治療すると、視力回復する可能性が高くなります。しかし黄斑浮腫が長く続いて、網膜にダメージが起こると、視力の回復は難しいです。
もう片方の目にも発症する可能性はありますか?
多くの場合は高血圧などの全身的な病気による動脈硬化が原因です。残念ながらもう片方の目にも起こる可能性はあります。定期的な通院を続けてください。
網膜静脈閉塞になったら、運動は控えた方がいいでしょうか?
症状が激しい急性期には控えた方がいいでしょう。しかし原因となっている高血圧や糖尿病・高脂血症をコントロールするためには運動も必要です。
医師と相談しながら指示に従ってください。